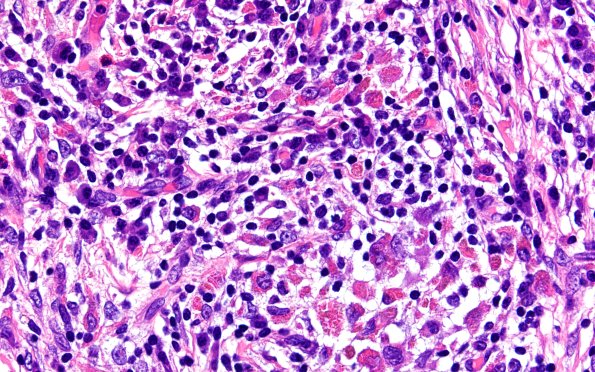
24B8 LCH (Case 24) H&E 40X 6

Table of Contents
Washington University Experience | NEOPLASMS (HEMATOLYMPHOID) | Langerhans Cell Histiocytosis (LCH) | 24B8 LCH (Case 24) H&E 40X 6
24B8-10 In some places there are unusual collections of shards of eosinophilic material (arrows, 24B10) which likely represent Charcot-Leyden crystals. (H&E)